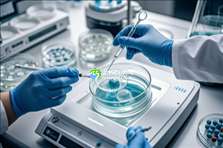

特别提示:接受试管婴儿技术的夫妇必须是合法夫妻,且仅限于治疗因特定不孕不育问题而无法通过其他方式怀孕的夫妇。
申请做试管助孕的人多不多?哪些人可以做试管婴儿
申请做试管助孕的人多不多?哪些人可以做试管婴儿。现在申请做试管婴儿的人还是比较多的。需要知道的是,试管助孕一般是针对患有少精症、弱精症、无精症的男性,通常是使用精子存储医院中其他男性无偿的健康精子和女性的卵子结合形成早期胚胎,然后再移植到女性的宫腔内进行着床,能够进一步提高试管的成功率。但是目前精子存储医院的精子是比较紧缺的,所以需要提前进行申请。
申请做试管助孕的人多不多?哪些人可以做试管婴儿。现在申请做试管婴儿的人还是比较多的。需要知道的是,试管助孕一般是针对患有少精症、弱精症、无精症的男性,通常是使用精子存储医院中其他男性无偿的健康精子和女性的卵子结合形成早期胚胎,然后再移植到女性的宫腔内进行着床,能够进一步提高试管的成功率。但是目前精子存储医院的精子是比较紧缺的,所以需要提前进行申请。
2025男性申请做试管助孕的人多不多
2025男性申请做试管助孕的人多,但想要在国内精子存储医院做试管助孕,都需要排队3个月到半年的时间,因此有做试管助孕打算的夫妇可以先去登记排队
目前国内用医院供给的精子做试管婴儿的费用大约在3-5万元左右,不同的区域消费水平不一样、不同医院等级,试管助孕费用或许存在较大差异,具体费用需求以当地生殖医院收费规范为准。
试管助孕费用一般包含术前身体查看费,医院精子费、移植费、胚胎培育费、胚胎移植费以及验孕费等,运用医院供给的精子需求付出必定费用,假如一次移植不成功,进行屡次试管移植费用或许会更高。
哪些人可以做试管婴儿
据相关数据显示,中国不孕不育的发病率高达15%,不孕不育人群中20%的夫妇需要通过试管婴儿来孕育新生命。但对试管婴儿有什么限制吗?哪些人可以做试管婴儿,下面是详细的介绍。
1. 不可逆无精子症,精液离心后未发现精子,睾丸穿刺或显微取精也未发现精子;
2. 梗阻性无精子症,患者不愿睾丸从睾丸中取精,因为精子运输通道不畅或缺失(如输精管缺失),主动要求助孕治疗;
3. 极度少弱畸精子症,治疗无效,主动放弃自己的精子受精,要求助孕治疗;
4. 射精功能障碍(同房或手淫不能射精),治疗无效后,患者不愿意将睾丸取精作为试管婴儿,主动要求助孕;
5. 男方或家属患有遗传疾病,出生儿童可能有先天缺陷等,病人不愿做三代试管婴儿助孕;
6. 身体疾病严重,精神心理障碍,不能实现优生优育,病人主动要求助孕治疗;
7. 夫妻或母婴血型或免疫不相容,导致多次流产,婴儿发育异常,治疗无效;病人主动要求**。
注意,做试管婴儿**的几率并不高,其成功率主要还是和双方患者的身体情况与精子、卵子结合质量,还有宫腔里面的环境等等都有很大的关系,所以有可能一次不能成功,需要三到四次,如果是超过六次的话,那就属于失败,需要考虑其他的辅助生殖技术。
- 哈尔滨专业助孕公司联系电话,成功率费用明细
- 武汉值得信赖助孕机构排名前十榜单,2025年权威发布!
- 长沙十大专业助孕公司排行,附10家助孕公司联系信息
- 成都可靠助孕医院联系信息-成都最全助孕机构推荐
- 2025年助孕机构排名榜发布:北京十家评选完整名单,值得一试!
- 2025年沈阳助孕生子的优质私立医院推荐?附联系详情
- 厦门最大助孕中心联系电话,厦门三大正规助孕机构推荐
- 哈尔滨市排名前十的助孕机构盘点 哈尔滨较大规模的助孕医院有哪些
- 成都市三大助孕机构榜单前十,成都优质助孕机构
- 上海3大助孕公司排行榜最新发布,附联系信息
- 昆明正规助孕机构推荐,2025年值得信赖的助孕公司有哪些
- 上海三大优质助孕机构盘点,附联系电话及机构地址
- 昆明正规私立助孕机构有哪些?昆明助孕机构完整名单
- 广州助孕:广州正规助孕服务公司排名前十
- 2025南京值得信赖的第三方助孕机构名单一览
- 南京助孕机构如何选,这份推荐名单别错过